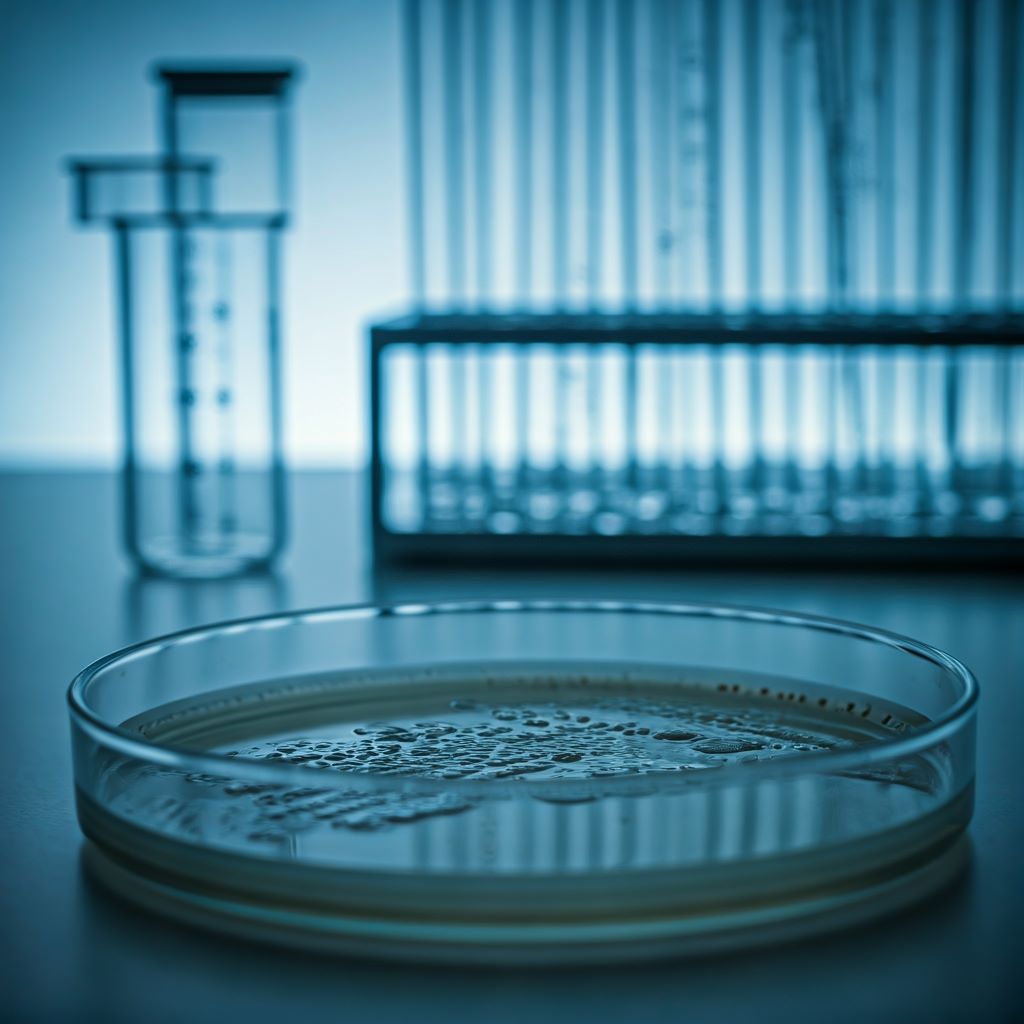
salmo-7

Сальмонеллёз
Сальмонеллёз - острая зоонозная кишечная инфекция, характеризующаяся поражением органов пищеварения с развитием синдрома интоксикации и водно-электролитных нарушений, реже - тифоподобным или септикопиемическим течением. Она вызывается различными серотипами бактерий рода сальмонелла, характеризуется разнообразными клиническими проявлениями от бессимптомного носительства до тяжелых септических форм. В большинстве случаев протекает с преимущественным поражением органов пищеварительного тракта (гастроэнтериты, колиты).
 Первых представителей рода обнаружил К. Эберт (1880) в пейеровых бляшках, селезёнке и лимфатических узлах человека, погибшего от брюшного тифа; чистую культуру возбудителя заболевания выделил Г. Гаффки (1884). Позднее Д.Е. Сэльмон и Дж. Т. Смит (1885) во время вспышки чумы свиней и А. Гертнер (1888) из говядины и селезёнки погибшего человека выделили сходные бактерии. В частности, Боллингер (1967), еще до выделения возбудителя, указывал на связь поражений с употреблением в пищу мяса больных животных. В начале XX века для возбудителей был организован отдельный род в составе семейства Enterobacteriaceae, получивший, в честь Сэльмона название Salmonella. Сальмонеллы представляют собой большую группу бактерий, систематика которых претерпевала значительные изменения по мере совершенствования знаний об их антигенной структуре и биохимических свойствах. В начале 30-х годов Ф. Кауффманн и П. Уайт предложили разделять сальмонеллы в соответствии с их антигенной структурой; в настоящее время её применяют для дифференцировки сальмонелл.
Первых представителей рода обнаружил К. Эберт (1880) в пейеровых бляшках, селезёнке и лимфатических узлах человека, погибшего от брюшного тифа; чистую культуру возбудителя заболевания выделил Г. Гаффки (1884). Позднее Д.Е. Сэльмон и Дж. Т. Смит (1885) во время вспышки чумы свиней и А. Гертнер (1888) из говядины и селезёнки погибшего человека выделили сходные бактерии. В частности, Боллингер (1967), еще до выделения возбудителя, указывал на связь поражений с употреблением в пищу мяса больных животных. В начале XX века для возбудителей был организован отдельный род в составе семейства Enterobacteriaceae, получивший, в честь Сэльмона название Salmonella. Сальмонеллы представляют собой большую группу бактерий, систематика которых претерпевала значительные изменения по мере совершенствования знаний об их антигенной структуре и биохимических свойствах. В начале 30-х годов Ф. Кауффманн и П. Уайт предложили разделять сальмонеллы в соответствии с их антигенной структурой; в настоящее время её применяют для дифференцировки сальмонелл.
Этиология
Возбудители сальмонеллеза - грамотрицательные подвижные палочки, но существуют и неподвижные мутанты и серовары.
Род Salmonella семейства Enterobacteriaceae объединяет более 2300 сероваров, разделённых по набору соматических О-антигенов на 46 серогрупп. По структуре Н-антигена выделяют около 2500 сероваров.
Сальмонеллы длительно сохраняются во внешней среде: в воде до - 5 месяцев, в мясе - около 6 месяцев, в птичьих тушках до года и более, в колбасных изделиях – от 2 до 4 месяцев. Около 20 дней сохраняются в молоке, кефире - до 1 месяца, в сливочном масле - до 4 месяцев, в сырах - до 1 года, в яичном порошке - от 3 до 9 месяцев, на яичной скорлупе - от 17 до 24 дней, в пиве - до 2 мес, в почве - до 18 мес. Экспериментально установлено, что при длительном (свыше месяца) хранении куриных яиц в холодильнике S. enteritidis может проникать внутрь яиц через неповреждённую скорлупу и размножаться в желтке. Погибают сальмонеллы при температуре 80°С в течение 3 минут, при 100°С – мгновенно. При варке яиц погибают через 4 минуты. В молоке и мясных продуктах сальмонеллы не только сохраняются, но и активно размножаются, при этом не влияя на органолептические свойства продуктов. Соление и копчение не убивают сальмонеллы. Засолка способствует гибели микроорганизмов только при концентрации соли более 18%.
Эпидемиология сальмонеллеза
Резервуар и источники инфекции - многие виды сельскохозяйственных и диких животных и птиц; у них болезнь может протекать в виде выраженных форм, а также бессимптомного носительства. Важнейшим источником инфекции при сальмонеллёзах является крупный рогатый скот, а также свиньи, инфицированность которых может достигать 50%.  Заражение человека происходит при уходе за животными, употреблением в пищу инфицированного мяса крупного рогатого скота, птицы, яиц, а также молока и молочных продуктов. Носительство сальмонелл отмечено у кошек и собак (10%), а также среди синантропных грызунов (до 40%). Сальмонеллёз широко распространён среди диких птиц (голуби, скворцы, воробьи, чайки и др.). При этом птицы могут загрязнять помётом и тем самым контаминировать предметы внешней обстановки и пищевые продукты. В последние 30 лет в большинстве стран мира отмечается резкое увеличение числа положительных находок сальмонелл у сельскохозяйственных птиц и в первую очередь кур.
Заражение человека происходит при уходе за животными, употреблением в пищу инфицированного мяса крупного рогатого скота, птицы, яиц, а также молока и молочных продуктов. Носительство сальмонелл отмечено у кошек и собак (10%), а также среди синантропных грызунов (до 40%). Сальмонеллёз широко распространён среди диких птиц (голуби, скворцы, воробьи, чайки и др.). При этом птицы могут загрязнять помётом и тем самым контаминировать предметы внешней обстановки и пищевые продукты. В последние 30 лет в большинстве стран мира отмечается резкое увеличение числа положительных находок сальмонелл у сельскохозяйственных птиц и в первую очередь кур.
Человек может быть источником некоторых видов сальмонелл (S. typhimurium и S. haifa), особенно в условиях стационаров. Наибольшую опасность человек (больной или носитель) представляет для детей первого года жизни, отличающихся особой восприимчивостью к сальмонеллам. Длительность заразного периода у больных определяет срок и характер болезни; он может продолжаться у животных месяцами, а у человека - от нескольких дней до 3 недель. Реконвалесцентное носительство у людей иногда может длиться до года.
Механизм передачи - фекально-оральный, основной путь передачи - пищевой, главным образом через продукты животного происхождения. Наиболее значимы мясные блюда, приготовленные из фарша, и мясные салаты; меньшее значение имеют рыбные и растительные продукты. Водный путь передачи играет роль в заражении животных в животноводческих комплексах и на птицефабриках. Контактно-бытовой путь передачи (через заражённые предметы обихода, полотенца, игрушки, горшки, пеленальные столики, манежи, руки медицинского персонала и матерей) играет наибольшую роль в стационарах, особенно в родильных, педиатрических отделениях. Факторами передачи могут оказаться и медицинский инструментарий, оборудование (катетеры, эндоскопы и др.) при нарушении режима их стерилизации.
Исход заражения сальмонеллами во многом зависит от дозы микроорганизмов, их сероваровой принадлежности и других биологических свойств, а также от индивидуальных особенностей организма человека, иммунитета и других факторов. Средняя инфицирующая доза сальмонелл может составлять 106-107 микробных клеток. Наибольшей чувствительностью к сальмонеллезным инфекциям обладают дети первого года жизни и пожилые люди, ослабленные хроническими заболеваниями.
Сальмонеллёз относят к числу повсеместно распространённых инфекций, в последние годы отмечают тенденцию к дальнейшему росту заболеваемости. В отличие от большинства кишечных инфекций сальмонеллёзы наиболее широко распространены в крупных благоустроенных городах, в странах, характеризующихся высоким уровнем экономического развития, что позволяет отнести их к группе «болезней цивилизации». Сальмонеллёзы регистрируют в виде эпидемических вспышек и спорадических случаев; довольно часто даже при тщательном эпидемиологическом расследовании вспышки остаются нерасшифрованными. В последние годы отмечают значительный рост заболеваемости, связанной с распространением бактерий (S. enteritidis) через мясо птицы и яйца, а также продуктов, приготовленных из них. Среди заболевших людей преобладают взрослые (60-70%), хотя самый высокий интенсивный показатель заболеваемости отмечен среди детей раннего возраста. Высокая чувствительность детей раннего возраста к небольшим дозам возбудителя предопределяет возможность передачи его среди них не только пищевым, но и так называемым бытовым путём. Вспышки носят, как правило, взрывной характер. Заболеваемость сальмонеллёзами возрастает в тёплое время года.
Патогенез сальмонеллеза
Сальмонеллы, преодолев факторы неспецифической защиты ротовой полости и желудка, попадают в просвет тонкой кишки, где прикрепляются к мембранам энтероцитов и выделяют термостабильный и/или термолабильный экзотоксины. С помощью факторов проницаемости (гиалуронидазы) возбудители через щёточную кайму проникают внутрь энтероцитов. Взаимодействие бактерий с эпителиальными клетками приводит к дегенеративным изменениям микроворсинок. Интервенции возбудителей в подслизистый слой кишечной стенки противодействуют фагоциты, что сопровождается развитием воспалительной реакции.
Клиника сальмонеллеза и его осложнения
Инкубационный период колеблется от 6 ч до 3 суток (чаще 12—24 ч). Различают следующие клинические формы сальмонеллеза: гастроинтестинальную (локализованную), протекающую по гастритическому, гастроэнтеритическому и гастроэнтероколитическому вариантам; генерализованную в виде тифоподобного и септического вариантов; бактерионосительство (острое, хроническое и транзиторное).
 Гастроинтестинальная форма встречается наиболее часто (до 90% всех случаев). Болезнь начинается остро, повышается температура тела, появляются общая слабость, головная боль, озноб, тошнота, рвота, боли в эпигастральной области, понос. При гастритическом варианте болезни боли локализуются в эпигастральной области, наблюдается рвота, диарея отсутствует. Этот вариант встречается редко. При наиболее частом, гастроэнтеритическом варианте болезни отмечаются рвота, частый водянистый стул, боли локализуются в эпигастрии и мезогастрии. При гастроэнтероколитическом варианте на 2—3-й день болезни появляются болезненность сигмовидной кишки, тенезмы, в кале — примесь слизи и крови. При легком течении болезни температура тела субфебрильная, испражнения жидкие, водянистые, стул до 5 раз в сутки, длительность поноса 1—3 дня, потеря жидкости не более 3% массы тела. При среднетяжелом течении болезни температура повышается до 38—39°, длительность лихорадки до 4 суток, отмечаются повторная рвота, стул до 10 раз в сутки, длительность поноса до 7 дней. Характерны тахикардия, понижение АД. Потеря жидкости достигает 6% массы тела. При тяжелом течении болезни лихорадка выше 39°, длительность ее 5 суток и более. Рвота многократная, в течение нескольких дней; стул более 10 раз в сутки, испражнения обильные, водянистые, зловонные, могут быть с примесью слизи. Понос продолжается более 7 суток. Отмечается увеличение печени и селезенки, может быть иктеричность кожи и склер. Наблюдаются цианоз кожи, снижение ее тургора, судороги, осиплость голоса, афония, тахикардия, значительное падение АД. Выявляются изменения почек: олигурия, альбуминурия, эритроциты и цилиндры в моче. При потере жидкости до 7—10% массы тела и более развивается картина гиповолемического шока.
Гастроинтестинальная форма встречается наиболее часто (до 90% всех случаев). Болезнь начинается остро, повышается температура тела, появляются общая слабость, головная боль, озноб, тошнота, рвота, боли в эпигастральной области, понос. При гастритическом варианте болезни боли локализуются в эпигастральной области, наблюдается рвота, диарея отсутствует. Этот вариант встречается редко. При наиболее частом, гастроэнтеритическом варианте болезни отмечаются рвота, частый водянистый стул, боли локализуются в эпигастрии и мезогастрии. При гастроэнтероколитическом варианте на 2—3-й день болезни появляются болезненность сигмовидной кишки, тенезмы, в кале — примесь слизи и крови. При легком течении болезни температура тела субфебрильная, испражнения жидкие, водянистые, стул до 5 раз в сутки, длительность поноса 1—3 дня, потеря жидкости не более 3% массы тела. При среднетяжелом течении болезни температура повышается до 38—39°, длительность лихорадки до 4 суток, отмечаются повторная рвота, стул до 10 раз в сутки, длительность поноса до 7 дней. Характерны тахикардия, понижение АД. Потеря жидкости достигает 6% массы тела. При тяжелом течении болезни лихорадка выше 39°, длительность ее 5 суток и более. Рвота многократная, в течение нескольких дней; стул более 10 раз в сутки, испражнения обильные, водянистые, зловонные, могут быть с примесью слизи. Понос продолжается более 7 суток. Отмечается увеличение печени и селезенки, может быть иктеричность кожи и склер. Наблюдаются цианоз кожи, снижение ее тургора, судороги, осиплость голоса, афония, тахикардия, значительное падение АД. Выявляются изменения почек: олигурия, альбуминурия, эритроциты и цилиндры в моче. При потере жидкости до 7—10% массы тела и более развивается картина гиповолемического шока.
Генерализованная форма при тифоподобном варианте болезни начинается остро, иногда с появления рвоты, поноса, лихорадки, общей интоксикации, но через 1—2 дня кишечные расстройства проходят, температура тела остается высокой, нарастают симптомы общей интоксикации. У большинства больных по началу и течению заболевание сходно с брюшным тифом. Лихорадка может быть постоянного типа, но чаще волнообразная или ремиттирующая; длительность лихорадки 1—3 недели. Больные заторможены, апатичны, лицо бледное. С 6—7-го дня появляется розеолезная сыпь с преимущественной локализацией на коже живота. Наблюдаются относительная брадикардия, понижение АД, приглушение тонов сердца. Над легкими выслушиваются рассеянные сухие хрипы. Живот вздут, печень и селезенка увеличены. Рецидивы наблюдаются редко. Возможны и легкие формы болезни с длительностью лихорадки 3—4 дня.
Септический вариант болезни наиболее тяжелый. Заболевание начинается остро, в первые дни имеет тифоподобное течение. В дальнейшем состояние больных ухудшается. Температура тела характеризуется большими суточными размахами, отмечаются повторный озноб и обильное потоотделение. Болезнь плохо поддается антибиотикотерапии. Вторичные септические очаги могут образоваться в различных органах и выступать в симптоматике на первый план. Гнойные очаги часто развиваются в опорно-двигательном аппарате: остеомиелиты, артриты. Иногда наблюдаются септический эндокардит, аортит с последующим развитием аневризмы аорты. Относительно часто возникают холецистохолангит, тонзиллит, менингит. Реже встречаются гнойные очаги других локализаций (абсцесс печени, струмит, мастоидит). Сальмонеллезный сепсис характеризуется длительным течением.
После перенесенного сальмонеллеза может сформироваться острое и хроническое бактерионосительство. Острым бактерионосительством принято считать выделение возбудителей от 15 дней до 3 месяцев. после клинического выздоровления, хроническим — более 3 месяцев. Транзиторным бактерионосительство является в тех случаях когда при отсутствии клинических признаков болезни в настоящее время и в предшествующие 3 месяца имеет место одно- или двукратное выделение возбудителя при отрицательных результатах серологического исследования в динамике.
Диагноз основывается на клинической картине, данных эпидемиологического анамнеза (указание на потребление пищи, которая могла быть фактором передачи сальмонелл). Диагноз подтверждается выделением сальмонелл из употреблявшихся больным продуктов, а также из рвотных масс, фекалий; при генерализованной форме — из крови и гноя вторичных очагов. Менее информативны серологические исследования (реакция агглютинации, РНГА при диагностическом титре 1:160 и выше).
Лабораторная диагностика
Для лабораторной диагностики сальмонеллезов используются бактериологические и серологические методы.
Материалом для исследования служат: кровь больного (при генерализованных формах), испражнения, рвотные массы и промывные воды желудка, желчь (дуоденальное содержимое), моча, секционный материал. Дополнительные объекты исследования - остатки пищи, употреблявшейся заболевшими, исходные продукты и полуфабрикаты, используемые для ее приготовления, суточные пробы готовой пищи, корма животного и растительного происхождения, смывы с оборудования и других предметов, подозреваемых в качестве фактора передачи возбудителя.
Материалом для исследования служат: кровь больного (при генерализованных формах), испражнения, рвотные массы и промывные воды желудка, желчь (дуоденальное содержимое), моча, секционный материал. Дополнительные объекты исследования - остатки пищи, употреблявшейся заболевшими, исходные продукты и полуфабрикаты, используемые для ее приготовления, суточные пробы готовой пищи, корма животного и растительного происхождения, смывы с оборудования и других предметов, подозреваемых в качестве фактора передачи возбудителя.
При серологическом методе применяют реакцию агглютинации (РА) - минимальный диагностический титр 1:200, реакцию непрямой гемагглютинации (РНГА) диагностический титр 1:160 и реакцию связывания комплемента (РСК) - диагностический титр 1:80. Реакции оцениваются по нарастанию титра антител в динамике. Специфические антитела в крови при сальмонеллезе появляются обычно к 6-8 дню от начала болезни, затем титр их нарастает.
При бактериологическом исследовании общим требованиям к процедуре отбора проб клинического материала является обеспечение условий, исключающих контаминацию материала микроорганизмами из смежных областей тела и окружающей среды. Судна, горшки и другие емкости для сбора испражнений должны быть тщательно вымыты и лишены следов дезинфицирующих средств.
Эпидемиологический надзор
Ведущее значение в профилактике сальмонеллёза принадлежит сочетанному эпидемиолого-эпизоотологическому надзору, осуществляемому ветеринарной и санитарно-эпидемиологической службами. Ветеринарная служба ведёт постоянное наблюдение за заболеваемостью животных, частотой инфицирования кормов и мясопродуктов, осуществляет микробиологический мониторинг за серологической структурой выделяемых сальмонелл и их биологическими свойствами. Санитарно-эпидемиологическая служба проводит наблюдение за заболеваемостью людей, её тенденциями и особенностями в определённый отрезок времени и на данной территории, осуществляет слежение за серотиповой структурой возбудителя, выделяемого от людей и из пищевых продуктов, изучение биологических свойств сальмонелл. Большое значение имеют разработка надёжных методов диагностики и стандартизация процедур учёта и уведомления о случаях заболевания, а также контроль за поступающими в реализацию пищевыми продуктами, особенно завезёнными из других регионов страны или из-за рубежа.
 Основу профилактики сальмонеллёза среди людей составляют ветеринарно-санитарные мероприятия, направленные на обеспечение надлежащих условий в процессе убоя скота и птицы, соблюдение режима убоя животных, технологии обработки туш, приготовления и хранения мясных и рыбных блюд. Большое значение имеют регулярный выборочный контроль кормов и кормовых ингредиентов, плановое осуществление дезинфекционных и дератизационных мероприятий на мясоперерабатывающих предприятиях, пищевых и сырьевых складах, холодильниках, вакцинация сельскохозяйственных животных. В общественном питании и личной домашней практике следует строго соблюдать санитарно-гигиенические правила приготовления пищи, раздельной обработки сырого мяса и варёных продуктов, условия и сроки хранения готовой пищи. Сигналом к проведению специальных противоэпидемических мероприятий являются нарастание числа выделений штаммов сальмонелл одного и того же серовара, появление новых или увеличение числа выделений сальмонелл, редко встречающихся на данной территории сероваров: увеличение доли штаммов, устойчивых к действию антибиотиков, возникновение вспышки сальмонеллёза. Для профилактики внутрибольничного инфицирования следует соблюдать все требования санитарно-гигиенического и противоэпидемического режима в лечебно-профилактических учреждениях. Лица, впервые поступающие на работу в детские дошкольные учреждения и лечебно-профилактические учреждения, на предприятия пищевой промышленности и приравненные к ним учреждения подлежат обязательному бактериологическому обследованию.
Основу профилактики сальмонеллёза среди людей составляют ветеринарно-санитарные мероприятия, направленные на обеспечение надлежащих условий в процессе убоя скота и птицы, соблюдение режима убоя животных, технологии обработки туш, приготовления и хранения мясных и рыбных блюд. Большое значение имеют регулярный выборочный контроль кормов и кормовых ингредиентов, плановое осуществление дезинфекционных и дератизационных мероприятий на мясоперерабатывающих предприятиях, пищевых и сырьевых складах, холодильниках, вакцинация сельскохозяйственных животных. В общественном питании и личной домашней практике следует строго соблюдать санитарно-гигиенические правила приготовления пищи, раздельной обработки сырого мяса и варёных продуктов, условия и сроки хранения готовой пищи. Сигналом к проведению специальных противоэпидемических мероприятий являются нарастание числа выделений штаммов сальмонелл одного и того же серовара, появление новых или увеличение числа выделений сальмонелл, редко встречающихся на данной территории сероваров: увеличение доли штаммов, устойчивых к действию антибиотиков, возникновение вспышки сальмонеллёза. Для профилактики внутрибольничного инфицирования следует соблюдать все требования санитарно-гигиенического и противоэпидемического режима в лечебно-профилактических учреждениях. Лица, впервые поступающие на работу в детские дошкольные учреждения и лечебно-профилактические учреждения, на предприятия пищевой промышленности и приравненные к ним учреждения подлежат обязательному бактериологическому обследованию.
Заключение
На данный момент проблема сальмонеллезов остается актуальной, поэтому, чем выше уровень лабораторных исследований, тем обоснованней заключение о причинах возникновения эпидемиологической ситуации и, следовательно, более обоснованными будут планируемые противоэпидемические и профилактические мероприятия.
Результаты лабораторных исследований являются важным и объективным мерилом степени распространения инфекции и создают основу не только для планирования, анализа, проведения и оценки результатов профилактических и противоэпидемических мероприятий, но и помогают выявлению изменений в характере развития эпидемиологического процесса заболевания.

























.png)



